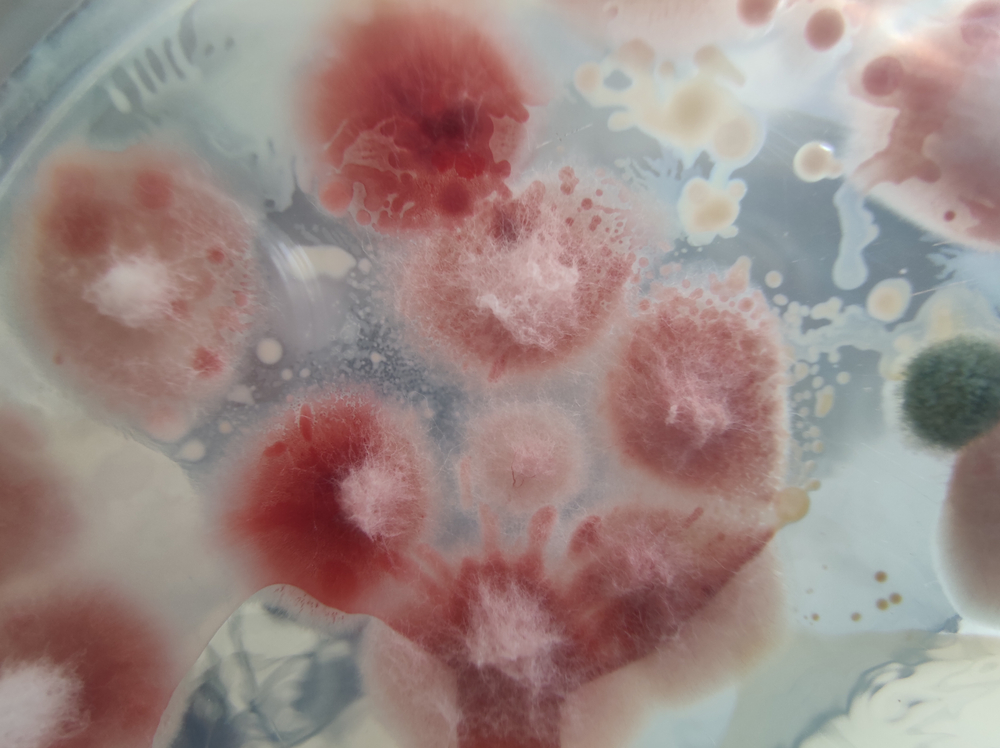

Żywienie kliniczne w pediatrii: między koniecznością a standardem opieki
Artykuł Redakcyjnyrozmowa z prof. dr hab. med. Agnieszką Szlagatys-Sidorkiewicz, prezes Polskiego Towarzystwa Żywienia Klinicznego Dzieci

Szanowni Państwo
Jako Członek Rady Naukowej czasopisma „Leczenie Żywieniowe” oraz Prezes Polskiego Towarzystwa Żywienia Klinicznego, z przyjemnością przedstawiam Państwu magazyn „Leczenie Żywieniowe” – wartościowe i potrzebne źródło wiedzy dla środowiska medycznego w Polsce.
„Leczenie Żywieniowe” jest praktycznym magazynem edukacyjnym, w całości poświęconym zagadnieniom terapii żywieniowej, wydawanym pod patronatem Polskiego Towarzystwa Żywienia Klinicznego (PTŻK) oraz Polskiego Towarzystwa Żywienia Klinicznego Dzieci (PTŻKD).
Czasopismo stanowi istotne wsparcie dla lekarzy oraz członków zespołów terapeutycznych zaangażowanych w kompleksową opiekę nad pacjentami wymagającymi interwencji żywieniowych. Na jego łamach publikowane są najnowsze doniesienia naukowe, rekomendacje ekspertów oraz praktyczne rozwiązania kliniczne, które znajdują bezpośrednie zastosowanie w codziennej praktyce lekarskiej.
Na szczególne podkreślenie zasługuje interdyscyplinarny charakter magazynu oraz jego koncentracja na nowoczesnych metodach leczenia żywieniowego, obejmujących m.in. wsparcie żywieniowe w onkologii, leczenie żywieniowe w chorobach przewlekłych, prehabilitację, a także leczenie żywieniowe dojelitowe i pozajelitowe.
„Leczenie Żywieniowe” to nie tylko źródło rzetelnej wiedzy, ale również ważna platforma wymiany doświadczeń pomiędzy specjalistami różnych dziedzin medycyny, wspierająca podnoszenie standardów opieki nad pacjentem i poprawę wyników leczenia.
Z wyrazami szacunku,
dr hab. n. med. prof. UML Przemysław Matras
Prezes Polskiego Towarzystwa Żywienia Klinicznego
Członek Rady Naukowej „Leczenie Żywieniowe”


rozmowa z prof. dr hab. med. Agnieszką Szlagatys-Sidorkiewicz, prezes Polskiego Towarzystwa Żywienia Klinicznego Dzieci



Choroby zapalne jelit (IBD) to grupa schorzeń obejmująca zarówno wrzodziejące zapalenie jelita grubego (UC), jak i chorobę Leśniowskiego-Crohna (CD), których częstość występowania na całym świecie wzrosła w ostatniej dekadzie1 . U osób dotkniętych tymi chorobami dochodzi do nawracającej i przewlekłej postaci, charakteryzującej się patologiczną aktywacją układu odpornościowego i przewlekłym stanem zapalnym przewodu pokarmowego (GI), co poważnie zaburza jego funkcjonowanie. Wśród typowych objawów IBD można wyróżnić krwawienie, biegunkę, ból brzucha oraz tzw. objawy pozajelitowe, do których należą bóle stawów, manifestacje skórne i zaburzenia ze strony centralnego układu nerwowego o typie depresji czy zaburzeń lękowych. Zarówno w przypadku CD, jak i UC, zapalenie jelit wiąże się z naruszeniem integralności i funkcji bariery jelitowej.

Nieswoiste choroby zapalne jelit (IBD), obejmujące przede wszystkim rzodziejące zapalenie jelita grubego oraz chorobę Leśniowskiego-Crohna, to przewlekłe schorzenia o podłożu immunologicznym, które prowadzą do nawracającego stanu zapalnego przewodu pokarmowego. Ich obraz kliniczny obejmuje m.in. biegunkę, ból brzucha, krwawienia z przewodu pokarmowego oraz utratę masy ciała, a rozpoznanie wymaga połączenia badań laboratoryjnych, histopatologicznych, endoskopii i obrazowania. Kluczowym celem współczesnego leczenia jest nie tylko kontrola objawów, ale przede wszystkim trwałe wygaszenie procesu zapalnego i zapobieganie uszkodzeniom jelit.

Nieswoiste choroby zapalne jelit (IBD) stanowią grupę przewlekłych schorzeń o złożonej etiologii, w których przebiegu kluczową rolę odgrywa przewlekły stan zapalny oraz zaburzenia mikrobioty jelitowej. Coraz większe znaczenie w terapii tych chorób przypisuje się postępowaniu żywieniowemu i odpowiednio dobranej suplementacji, które stanowią istotne wsparcie leczenia farmakologicznego. Aktualne dane wskazują, że interwencje dietetyczne mogą wpływać nie tylko na przebieg choroby, ale także na częstość zaostrzeń i jakość życia pacjentów.

Dieta CDED redefiniuje rolę żywienia w chorobie Leśniowskiego-Crohna, przesuwając je z obszaru wsparcia w stronę pełnoprawnej metody terapeutycznej. Oparta na eliminacji prozapalnych składników diety i połączona z częściowym żywieniem dojelitowym, pozwala skutecznie indukować remisję przy lepszej tolerancji niż klasyczne EEN.
Narodowy Instytut Onkologii – Państwowy Instytut Badawczy, Oddział w Gliwicach Przychodnia Przykliniczna – Poradnia Żywieniowa oraz Poradnia Żywienia Dojelitowego w Warunkach Domowych